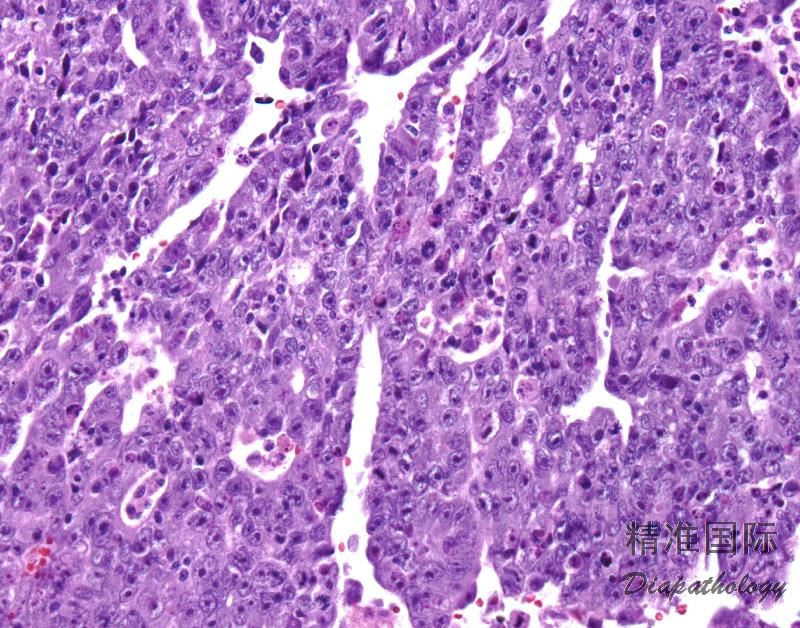

卵巢胚胎性癌
Embryonal Carcinoma of the Ovary
概述:
发生于卵巢的原始生殖细胞肿瘤伴有上皮分化,等同于睾丸的胚胎性癌。
发病部位: 卵巢
诊断要点:
几乎总发生在儿童及年轻成人,当胚胎性癌含有合体滋养细胞时,可表现内分泌症状,如儿童同性性早熟,成人阴道异常流血;
肿瘤细胞实性片状或巢状增生伴灶状腺样分化,在分化较好的肿瘤,除了形成实性区域外,瘤细胞还会衬覆裂隙和空腔,并形成乳头;
细胞中等到大,胞膜清楚,多边形或卵圆形,胞质丰富,淡染或嗜酸性颗粒状;细胞核大而明显,居中,空泡状或深染,有一定程度的不规则性。核膜清楚,一个或两个大的核仁。核分裂像和凋亡易见,异常核分裂像常见;
通常细胞多形性明显。可见巨细胞及多核细胞;
大多数病例可见合体滋养细胞;
局灶坏死、出血较常见。
免疫组织化学染色:
常表达 CK、CD30. OCT4. SALL4. Glypican3,SOX2 表达不一,EMA 阴性。
鉴别诊断:
无性细胞瘤:实性原始型胚胎性癌比较容易与无性细胞瘤混淆
存在裂隙、腺泡或有细胞被覆的腔隙等表现不支持无性细胞瘤的诊断;
胚胎性癌的瘤细胞通常更大,多形性更明显。核分裂更活跃,异常核分裂象更常见;
胚胎性癌的瘤细胞核膜不太清晰,胞核更不规则、更大,常含一个以上的深染核仁,而无性细胞瘤瘤细胞核仁圆而明显,通常为单个,常呈嗜酸性;
出现被淋巴细胞浸润的结缔组织间质和时而可见的肉芽肿反应是无性细胞瘤的突出特征,这些特征胚胎性癌通常缺乏;
免疫组化染色
诊断 | CK | CD117 | AFP | CD30 | OCT4 |
胚胎性癌 | 阳性 | 阴性 | 部分阳性 | 常阳性 | 总是阳性 |
无性细胞瘤 | 阴性 | 阳性 | 阴性 | 偶尔阳性 | 少数阳性 |
预后:
高度侵袭性,对化疗敏感